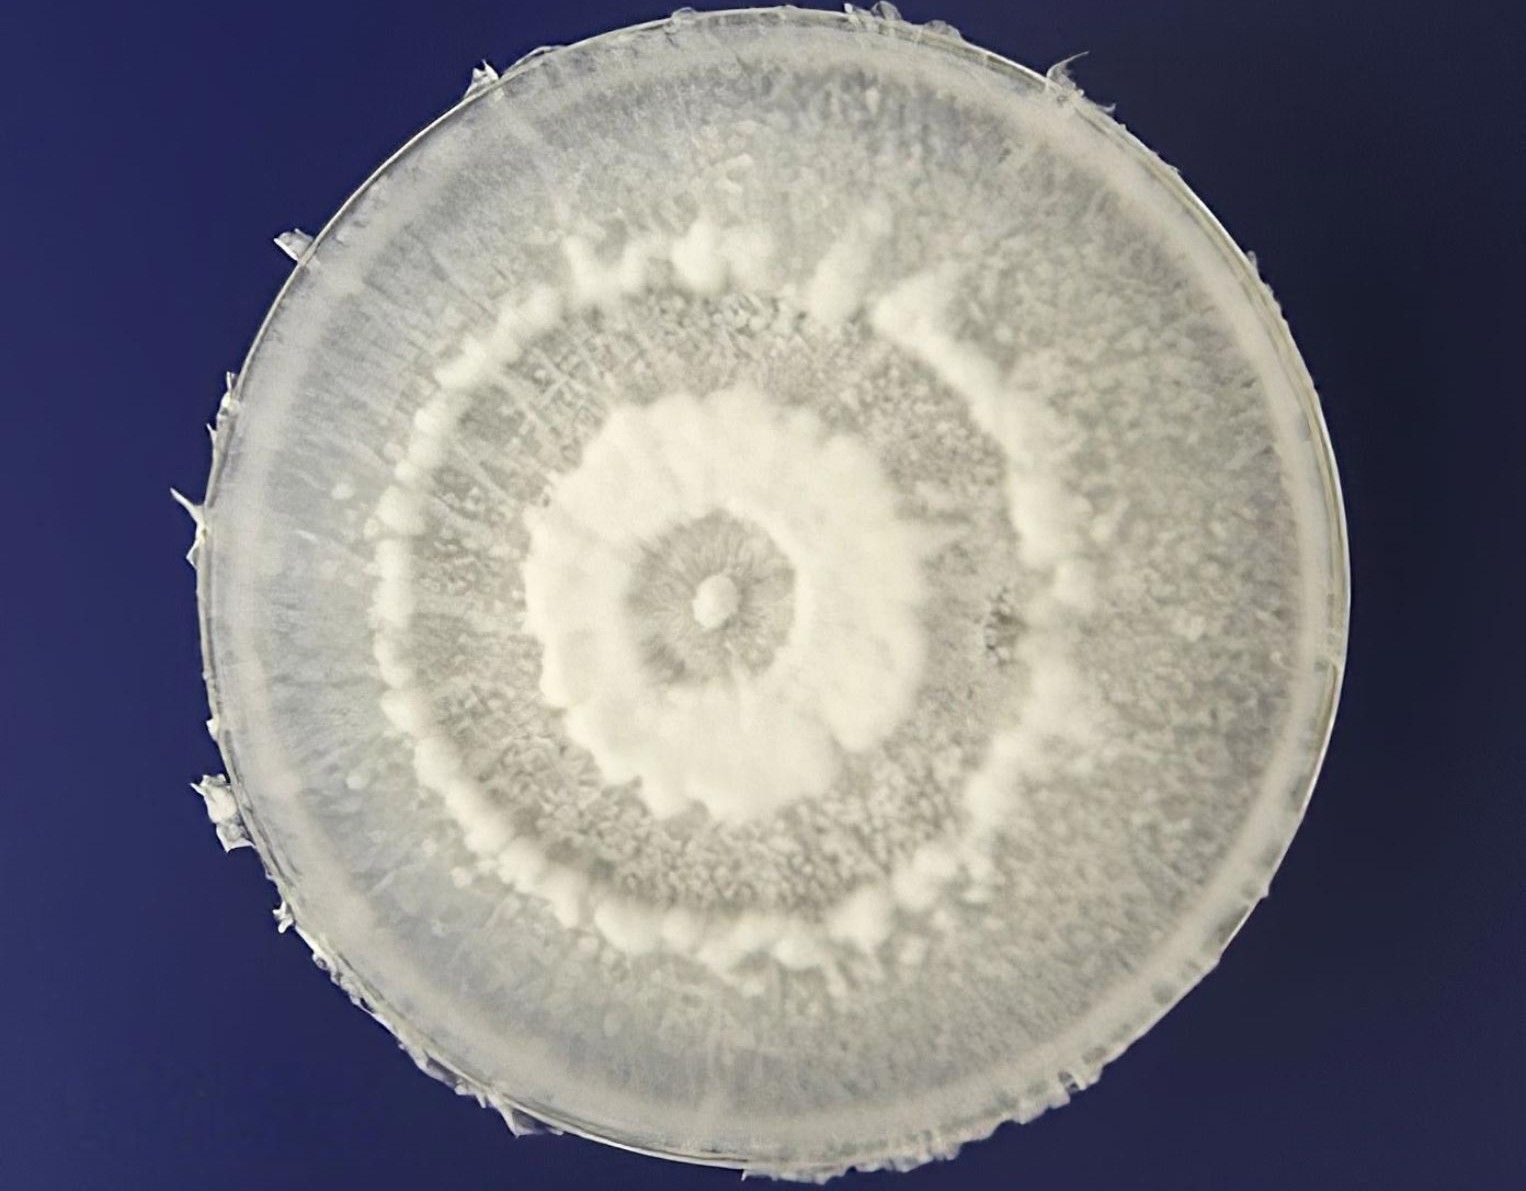

A fungus found in the Amazon, more specifically in Ecuador, represents hope in the fight against plastic pollution worldwide, currently considered the second greatest environmental threat to the planet, second only to the climate emergency. Named Pestalotiopsis microspora, the organism is capable of degrading one of the most resistant plastics to decomposition, polyurethane.
The fungus was discovered in 2011 by researchers from noth American Yale University during an expedition to Yasuní National Park in the Ecuadorian Amazon rainforest. The researchers, who were looking for microorganisms with biotechnological potential, observed that P. microspora, an endophytic fungus, i.e., one that lives inside plants, can “eat” plastic, whether in environments with or without oxygen, called aerobic or anaerobic, respectively.
The unique potentials to degrade polyurethane, even in anaerobic environments, makes P. microspora a promising solution for the use in landfills, whose deepest layers consist in environments without oxygen. Currently, 46% of the plastic produced on the planet ends up in landfills without being properly recycled.
DEGRADATION
It is already known that plastics take hundreds of years to degrade. Naturally, the breaking down of its constituent molecular chains is extremely slow, leaving these residues persistently in the environment. Polyurethane, which is used to make things ranging from foams for mattresses and cleaning sponges to shoe soles, is one of the most resistant materials to natural degradation. Without the intervention of expensive industrial methods or incineration, it can remain in landfills and dumps for centuries.
The discovery of an organism that helps in this process is encouraging. For pharmacist Thalita Calixto, who carried out a bibliographical study on the action of P. microspora at the Federal University of Ouro Preto, in Minas Gerais, nature has so much to offer in solving humanity's problems.
“We constantly have this proof. One example is biodegradation studies. Fungi and bacteria have enormous potential, already proven, to degrade certain types of plastic present in our daily lives, whether in plastic bags, PET bottles, synthetic fibers, paints, resins, among others. Developing biodegradation studies with these already known microorganisms, or making new discoveries, can significantly reduce the impact caused by plastic polymers discarded in the environment," says the researcher.
For Thalita, the advantage of the P. microspora, in addition to the degradation of polyurethane, even in anaerobic environments, is the production of bioactives used by the pharmaceutical industry, such as taxol, a substance used in the treatment of some types of cancer.
Biologist Ulisses Albino, a professor at the Federal University of Southern and Southeastern Pará (Unifesspa), points out that, in addition to the Ecuadorian Amazonian fungus, there are several others capable of digesting plastics. “A 2023 study provides a table with several examples of fungi with this property,” he says.
The mechanism developed as a means of survival
According to Thalita Calixto, the mechanism of action of P. microspora consists of secreting enzymes that are capable of breaking down the molecular structure of plastic polymers. “Then, these bonds, which were large, are transformed into smaller molecules that serve as food for the microorganism itself, or even into molecules that are less harmful to the environment,” explains the researcher.

According to Ulisses Albino, the great success of carbon polymers derived from petroleum, i.e., plastics, has to do with the fact that they do not have reactive “ends” where microorganisms or chemical reagents can attach themselves to cause reactions that lead to chain breaks.
"That's why plastic bags have replaced paper packaging, because they don't get damaged even if they get wet, they are more resistant to weight, among other characteristics. And, as these materials have been around for less time in nature, about one hundred years, fungi have not yet adapted enough to break them down with enzymes and acids, although some have already found weak points, such as P. microspora," he comments.
"But microorganisms are very smart in terms of making good use of available energy. Probably, the enzymes of P. microspora, already adapted to the long-chain compounds of host plants, were activated as a survival resource and broke down the plastics into fractions that could be absorbed by the cells. Then, inside the cells, they were used to generate energy. From what I have read, it is a fungus with many ‘tricks up its sleeve’ in its genome. Studies have already been published showing that they also produce antimicrobial and anticancer substances,” reports Albino.

Plastic is at the heart of a global crisis
Every year, according to the United Nations (UN), humanity produces around 460 million tons of plastic. In addition to almost half going to landfills, there is the volume that ends up in rivers and oceans, or even in groundwater, harming fauna, flora, and even human health. About 85% of the waste found in water bodies is plastic. More than 80 million tons have already accumulated in the seas. Brazil alone dumps 1.3 million tons of this type of waste into the oceans every year.
The problem is regarded as an urgent crisis, which is being addressed through initiatives such as the Global Treaty on Plastic Pollution, from the Intergovernmental Negotiating Committee, a UN forum created to discuss the situation. However, the last round of negotiations, held in August, ended without consensus, due to pressure from oil-producing countries, a material that makes up plastic.
In the Amazon, it is estimated that around 182,000 tons of plastic are dumped into its rivers each year. According to biologist José Eduardo Martinelli Filho, professor at the Federal University of Pará (UFPA) and coordinator of a research group that studies the pollution caused by plastics and microplastics in the Amazon, different experts rank the Amazon River basin between second and seventh place among the most polluted by plastic in the world.

“As cities in the Amazon grow and the use of plastic increases, this irregular disposal leads to a wide distribution of plastics and microplastics in the region, even far from cities, because these materials are carried by rivers, rainwater, and dispersed by humans and animals. There are plastic particles in the most remote areas,” warns Martinelli Filho.
RISKS
According to the Professor, there are non-toxic plastics, but there are others that, in their manufacturing process, take potentially toxic chemical additives, such as flame retardants or dyes. “For example, fishing nets made of nylon. Nylon itself is not toxic, but the blue dye added to fishing nets is potentially carcinogenic,” says the researcher.
In one of the studies conducted by the research group coordinated by Martinelli Filho, it was discovered that the japu bird has been using plastic debris, such as pieces of fishing nets, to build its nests."Generally, this bird uses natural fibers found in the environment for this purpose, but we noticed that it began to actively select fishing lines to build its nests, which turn blue because this nylon is usually blue. About 66% of the nests now contain some plastic, whether mixed with natural fibers or not. The concern is that this toxic blue dye may have an effect on the eggs and chicks," he says.
Microplastics are in the food chain
Over time, plastic objects discarded in the environment gradually break down into smaller and smaller pieces. These are called microplastics, particles smaller than five millimeters. Studies around the world demonstrate the omnipresence of microplastics, first identified inside aquatic organisms and other animals, but now known to be present in the human body, either through ingestion or inhalation. In humans, these particles have been found not only in the digestive tract, but also in the lungs and even in the blood. The possible health risks are not yet fully known, but they are concerning.

“There are plastics in different size ranges, such as microplastics and nanoplastics. The smaller the particle, the easier it is for it to be assimilated into the food chain, even by us humans. The fact that some plastics or their components are toxic represent a problem. In addition, when microplastics remain in the environment for a long time, they end up serving as a ‘home’ for bacteria, which can cause diseases in both animals and humans," warns Martinelli Filho.
“Studies have already proven that the presence of microplastics causes problems in the endocrine system of mice. Hormone production is affected. As this has been demonstrated in mammals, it could possibly have this effect in humans as well,” points out the researcher.
SOLUTIONS
Martinelli Filho sees great potential in fungi that can degrade plastic, such as P. microspora. "We can cultivate these fungi, isolate these enzymes, and produce this substance to attack plastic particles and help reduce these materials in the environment. But solutions start with environmental management, which is a problem especially in the Amazon, where there is no adequate collection, treatment, and disposal of solid waste. It is necessary to manage this waste efficiently and rethink consumption, which also involves public policies, such as banning plastic bags. We, as citizens, need to be aware of using cloth bags, for example. This way, we can reduce the use of plastic, especially single-use plastic, which is used once and then thrown away, only to remain in the environment for decades or centuries," affirms the professor.
INSTITUTIONAL PARTNERSHIP
The production of Liberal Amazon is one of the initiatives of the Technical Cooperation Agreement between the Liberal Group and the Federal University of Pará. The articles involving research from UFPA are revised by professionals from the academy. The translation of the content is also provided by the agreement, through the research project ET-Multi: Translation Studies: multifaces and multisemiotics.